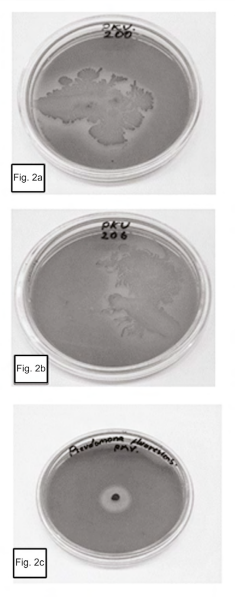
Strains that showed solubilization of phosphates: 2a. Bacillus subtilis GIBI 200 and 2b. Bacillus pumilus GIBI 206. 2c. Pseudomonas fluorescens GIBI 136 (positive control).

Artículos de Investigación
Bacillus EFFECT ON THE GERMINATION AND GROWTH OF TOMATO SEEDLINGS (Solanum lycopersicum L)
Efecto de Bacillus sobre la germinación y crecimiento de plántulas de tomate (Solanum lycopersicum L)
Bacillus EFFECT ON THE GERMINATION AND GROWTH OF TOMATO SEEDLINGS (Solanum lycopersicum L)
Acta Biológica Colombiana, vol. 22, no. 1, pp. 37-44, 2017
Universidad Nacional de Colombia

This work is licensed under Creative Commons Attribution 4.0 International.
Received: 11 May 2016
Accepted: 02 November 2016
Abstract: The capacity to solubilize phosphate and to produce indole compounds Indole Acetic Acid type, was evaluated in 15 strains isolated from castor bean lignocellulosic residues (Ricinus communis). To determine the solubilizing activity of phosphates a qualitative test by using Pikovskaya culture medium was employed and for the evaluation of the production of indole compounds (IAA) a Salkowsky colorimetric analysis technique was applied. Among the microorganisms tested, the Bacillus pumilus GIBI 206 demonstrated capacity to solubilize phosphates and Bacillus subtilis GIBI 200 showed of capacity to solubilize phosphates and to produce Indoleacetic Acid (IAA). To determine the effect of the Bacillus subtilis strain on germination and growth promotion, tomato seeds (Solanum lycopersicum 'Santa Clara') were inoculated; the inoculation of the seeds along with the microorganism revealed statistically significant differences, during the germination stage compared to the control treatment. Nevertheless, it revealed a positive influence on the development of tomato plants, originating a significant increase on the mass and length of its stem and root. The results of this research offer the possibility of using the Bacillus subtilis as a growth promoter in tomato seedlings and in the formulation of bio-products.
Keywords: biotechnology, indole, PGPB, seedlings, tomato.
Resumen: La capacidad para solubilizar fosfatos y producir compuestos indólicos del tipo Ácido Indol Acético, se evaluó en 15 cepas aisladas de residuos lignocelulósicos de higuerilla (Ricinus communis). Para determinar la actividad solubilizadora de fosfatos se realizó una prueba cualitativa utilizando medio de cultivo Pikovskaya y para evaluar la producción de compuestos indólicos (AIA) se empleó la técnica colorimétrica de Salkowsky. Entre los microorganismos evaluados, Bacillus pumilus GIBI 206 mostró tener la capacidad para solubilizar fosfatos y Bacillus subtilis GIBI 200 evidenció capacidad para solubilizar fosfatos y producir Ácido Indolacético (AIA). Para determinar el efecto de la cepa Bacillus subtilis sobre la germinación y promoción de crecimiento, se inoculó en semillas de tomate (Solanum lycopersicum cultivar Santa Clara); la inoculación de las semillas con el microorganismo no mostró diferencias estadísticamente significativas en el tiempo de germinación en comparación con el tratamiento control, sin embargo mostró influir positivamente en el desarrollo de las plantas de tomate generando un aumento significativo sobre la masa y longitud del tallo y de la raíz. Los resultados de esta investigación ofrecen la posibilidad de utilizar a Bacillus subtilis como promotora de crecimiento en plántulas de tomate y en la formulación de bioinsumos.
Palabras clave: biotecnología, indoles, PGPB, plántulas, tomate.
INTRODUCTION
The indiscriminate use of chemicals in agriculture has a negative impact on the environment, originating the accumulation of toxic substances, which pollute the soil, the water, and water tables, causing a biodiversity loss (Camelo et al., 2011). One of the strategies currently used for the agricultural clean production is the use of plant growth promoting bacteria (PGPR, plant growth promoting rhizobacteria (Cubillos et al., 2009).
The term PGPR was proposed to describe the bacteria that inhabit the plants rhizosphere and which have a positive effect on the crops (Kloepper and Schroth, 1993).
Subsequently, Bashan and Holguín (1998) proposed a new classification for the PGPR, which includes all the beneficial bacteria considering their particular role, to the extent that the term is divided into PGPR (plant growth promoting bacteria) and biocontrol-PGPB (biocontrol-plant growth promoting bacteria).
The PGPB can promote the plant growing through direct or indirect channels. The direct effects can be demonstrated in the absence of other microorganisms (that is, the plant only interacts with the microorganism under analysis), whereas the indirect mechanisms can be observed in the interaction between the microorganism of interest with a phytopathogenic, whereby the harmful effects on a plant are reduced (Acebo-Guerrero et al., 2015). The PGPB direct effects are: the phytohormone synthesis, the siderophores production, the mineral solubilization and the atmospheric nitrogen fixation (Estrada et al., 2013; Kaur and Reddy, 2014; Reis et al., 2015).
The influence on the absorption of mineral elements due to the raise of ionic flow on the radicular surface associated with PGPB has been also observed (Whipps, 2001). The biocontrol mechanisms widely recognized, mediated by PGPB, are the competition for nutrients or space, the inhibitory chemical compounds synthesis as the siderophores, the antibiotics, lythic enzymes, and biosurfactants (Acebo-Guerrero et al., 2015), as well as the induction of systemic acquired resistance in plants (Hernández-Rodríguez et al., 2014; Chandler et al., 2015).
A wide array of bacterial genre is considered within this classification: Pseudomonas, Burkholderia, Bacillus, Azospirillum, Herbaspirillum, Enterobacter and Azotobacter, among others (Kennedy et al., 2004). Several researches have informed the genres Pseudomonas, Azospirillum, Azotobacter, Bacillus and Streptomyces, as part of the tomato rhizosphere microbial community, being the genre of Azospirillum, the most predominant. Additionally, the effect of its inoculation on growth, its nutritional condition and performance is highlighted (Solanum lycopersicum L) (Terry-Alfonso et al., 2005; Widnyana Ketut and Cokorda Javandira, 2016), similarly, various species of the genre Bacillus have been used to confirm its capacity to promote plant growing in tomato plants. In this regard, Gül et al. (2008), used two commercial strains of Bacillus amyloliquefaciens (FZB24 and FZB42) to determine their effect on tomato production in closed and open systems, regarding the presence of different quantity of nutrients. Myresiotis (2014) demonstrated that tomato plants inoculated with a combination of the B. subtilis GB03 and B. pumilus SE34 strains enhanced the absorption of nutrients and the supression of pathogens.
In Colombia, 15 % of the horticultural area and 9.6 % of the fresh vegetables exported belong to tomato. In the year 2010, the area planted was of 16,227 ha, with a production of 546,322 t, and for the year 2013, the harvested area was of 16,704 ha, with a production of 683538 t, for a total average per year of 40.9 t/ha.(Arie et al., 2007; Morales et al., 2009; Ceballos et al., 2012). Considering Colombian diversity and its capacities of agricultural use, with emphasis in tomato crops, this study has the aim of determine the effect of native strains de Bacillus on the germination and the development of the diverse biometric parameters of tomato crops.
MATERIALS AND METHODS
Microbial cultures
Fifteen native bacterial strains were used, these strains were previously isolated from the castor bean lignocellulose residues (Ricinus communis) and characterized through traditional and molecular techniques by Cabra-Cendales et al. (2015). These strains are deposited in the microrganisms bank at The Catholic University of Manizales (UCM) with the codes GIBI 187, GIBI 188, GIBI 189, GIBI 192, GIBI 193, GIBI 194, GIBI 195, GIBI 197, GIBI 199, GIBI 200, GIBI 201, GIBI 203, GIBI 204, GIBI 206, GIBI 208. The strain with code GIBI 200 was inoculated in tomato seeds Santa Clara in order to confirm its effect on it.
Production of Indole compounds of Indole Acetic Acid (IAA) type
For a quantitative determination of the Indole compounds production, the bacteria to be evaluated were inoculated in Trypticase Soy Agar (TSA) supplemented with DL-Tryptophan 0.1/L as inductor of auxins production (Tien et al., 1979). They were incubated at 30 °C and kept under constant agitation at 120 rpm during 96 h. Successively, they were centrifuged for 10 minutes at 5000 rpm and the agar cultures free from cells were added with the Salkowski reactive (Glickmann et al., 1995) in a 1:2. relation. The incubation process was done at an above room-ambient condition temperature and darkness for 30 minutes; afterwards the absorbance was read at 540 nm with a spectrophotometer type Pharo300 by Merck. In parallel, a pattern curve was done with synthetic (IAA) in concentrations of μg.mL-1 to 30 μg.mL-1. The experiment was repeated three times with five replicas per strain.
Phosphate solubilizing
The capacity of phosphate solubilizing was determined in the Pikovskaya culture medium supplemented with Ca3 (PO4)2 (MercK). The plates were incubated at 30 ºC for seven days (Mehta and Nautiyal, 2001). As a positive control the bacteria Pseudomonas fluorescens GIBI 136 was used.
Bioassay of plant-microorganism interaction, peat and seeds inoculation
To prepare the bacterial inoculum a plates of nutritive agar was taken from the growing bacterium colony and suspended in 5ml of Trypticase Soy broth at pH 7.0. It was kept in agitation at 120 rpm and at 30 °C for 48 to 72 h. Afterwards, the 5 ml of Trypticase Soy broth were moved with the growing microorganism at 45 ml of the same culture medium. Subsequently, it was taken at a volume of 500 ml, incubated at 30 °C at constant agitation until achieving a concentration of 108 cells/ml. The concentration was verified through spectrophotometry at a wavelength (λ) of 600 nm seeking for an absorbance between 0.9 and 1 equivalent to a concentration of 1x108 c/mL and by counting the colony-forming units UFC/mL through the total viable count. The microorganism feasibility and purity tests were made in triplicate in Trypticase Soy Agar plates.
Commercial peat was used as substrate for planting seeds (Sphagnum), it sterilized was three times for one hour at 121 °C, afterwards, each kilogram was impregnated with 300 ml of the inoculum and incubated for 96 hours at 30 °C. Posterior to this, a count on the microorganism plate was done and a 7.9 x 108 UFC/g count was obtained.
Experimental Conditions
One hundred twenty (120) Solanum lycopersicum L. Santa Clara commercial seeds were disinfected in a sodium hypochlorite solution at 5 % for a minute, in ethanol at 70 % for a minute and after that, successive washes with sterile distilled water. Sixty seeds were inoculated with the microorganism solution in Trypticase Soy broth, with a concentration of 108 cells/ml. They were agitated for an hour at 120 rpm. As negative control sixty treated seeds with sterile distilled water were used (Reyes et al., 2008).
The seeds were planted at random in germination trays containing commercial peat coming from Canadian peatlands (Sphagnum), assigning a well to each of them randomly. Twelve grooves with ten seeds each distributed in six grooves with seeds and microorganism-inoculated peat and six grooves of negative control (peat seeds treated with Trypticase Soy (TS) only were established. Germination trays were watered with 2 ml sterile distilled water for nine days, after which the maximum of germination in treatments was obtained.
The seedlings obtained were left planted up to the age of 37 days where two real leaves had developed. Posterior to this, fifteen plants for treatment were selected at random and the following growing parameters were determined: longest root length, stem length, leaves and root moist and dry mass of matter, according to the Camargo and Ávila (2014) method.
Biometric Analysis
The design was completely randomized using as response variable the production of IAA and as a controlled factor the type of microorganism and the Duncan multiple range test was applied for multiple comparisons between treatments using SPSS version 19.0. The germination results were compared with respect to the control group (uninoculated seeds) using the SPSS 18.0 program. Subsequently, the method of Principal Component Analysis (PCA) was used, using the R 2.15.1 program in order to track the effect of microorganisms in various biometric indicators of the plant.
RESULTS
100 % of the strains (15) have the ability to produce indole compounds IAA type. However, only 13.3 % (2) solubilized phosphates. All strains produce low levels of IAA in the range of 2.49 to 5.47 µg / ml (Figure. 1). Bacillus subtilis strain GIBI 200 obtained the highest production average of this metabolite (5.47 µg / ml), whereas the Bacillus sp. strain GIBI 208 showed the lowest production value of IAA (2.49 µg / ml).
As for the solubilization of phosphates, only Bacillus subtilis GIBI 200 and Bacillus pumilus GIBI 206 showed halos around the colony, which shows that these strains have the potential to solubilize inorganic phosphate (Fig. 2). Bacillus subtilis strain GIBI 200 was selected to continue this study for their ability to produce IAA and solubilize phosphates, mechanisms that may be involved in the plant growth-promoting activity.

Figure 1
Verage concentration of indolic compounds type µl IAA. No common letters represent statistically significant differences (p <0.05) between strains used, according to Levene’s test of homogeneity of variances.
Figure 2
Strains that showed solubilization of phosphates: 2a. Bacillus subtilis GIBI 200 and 2b. Bacillus pumilus GIBI 206. 2c. Pseudomonas fluorescens GIBI 136 (positive control).
Effect of Bacillus subtilis strain GIBI 200 on tomato crop
The maximum germination of tomato seeds was obtained on day nine, for both inoculated and uninoculated seeds. The percentage of germination of inoculated seeds was 86.7 % (52 seeds) and of uninoculated was 80 % (48 seeds). No statistical significance between the inoculated tomato seeds and the control sample (p = 0.401) was demonstrated. However, high mortality was observed in the control seedlings (51.6 %, 31), while in inoculated plants it was 6.6 % (four seedlings), indicating that the inoculation with the strain Bacillus subtilis GIBI 200 reduced substantially seedling mortality.
The scattergram (Fig. 3) evidences a positive correlation between wet and dry root mass with a correlation coefficient of 0.9474. Similarly, it evidences a strong correlation between the wet and dry mass of the stem with a correlation coefficient of 0.8227. These high correlations indicate the presence of redundant information in the variables involved. Therefore, to improve the quality of the information reflected in the plane, this information (values of the wet mass of root and shoot) was deleted. Table.1 shows the correlation matrix of the variables that remain in the study.
The correlation among the variables involved indicates that a principal component analysis is appropriate to group quantitative variables that demonstrate interdependence. Table 2 shows that the first component retains 52.5 % of the variability, while the second component retains only 25.8 %, so the first factorial plane explains about 78.3 % of the total variability of the data. Furthermore, it is detected that the first two components are the only ones having eigenvalues that exceed 1.0, indicating that the first factorial plane is the illustrative enough to explain the interdependence present in the data studied, without a significant loss of information.
The factorial plane (Fig. 4) shows that in general, vectors that identify the variables have high magnitude, indicating that all the variables studied are well represented and confirms that the analysis of other factorial planes is not needed. The first principal component accounts for the size of the plants whose growth is registered to the left, that is, larger plants are located in the second and third quadrant, while smaller are located to the right of plane. The second component is an indicator of the shape of plants, and contrasts mainly the variables wet mass of root and stem length. This first factorial plane shows a positive impact associated with inoculation of tomato plants with Bacillus subtilis GIBI 200 related to the increase in stem and root lengths, as well as fresh mass of root and stem; if you consider that plants labeled with numbers 1 to 15 correspond to plants inoculated with the microorganism, whereas plants registered with the numbers 16 to 30 served as a control group. This first factorial plane shows that plants with high biophysical measurements are located in the quadrants of the left of the plane, which are mostly inoculated plants with the bacteria. It also shows a 0.7 and 0.74 mm increase for inoculated plants with respect to uninoculated plants, on their average stem and root lengths respectively. Similarly, increases in the other variables studied were recorded, although the only statistically significant differences (p<0.05) are the length and stem wet weight (Table 3)

Figure 3
Scattergram of the variables studied: Stem Length, Root Length, Wet Stem Weight, Dry Stem Weight, Wet Root Weight, Dry Root Weight.



Figure 4
First factorial plane of PCA with the variables retained.

DISCUSSION
Bacillus is one of the most studied genus due to the plant growth promoting capacity in crops of economic importance (Rojas et al., 2011; Hernández-Rodríguez et al, 2014; Myresiotis et al., 2014; Widnyana Ketut and Cokorda Javandira, 2016). These bacteria are not usually important producers of auxin, however, some strains with the capacity to produce between 16 and 55 µg/ml of IAA have been reported (Tsavkelova, 2006; Felici et al., 2008; Rojas et al., 2011). The genus Bacillus includes B.megaterium species and B. subtilis that can produce organic acids as primary mechanism of solubilization of phosphate, but may also act as phytases enzymes excreted into the culture medium (Fernandez et al., 2005).
In this research, the studied strains produce between 2.49 and 5.47 µg/ml IAA. These values are similar to those previously reported by Luna Martínez et al. (2013), who typified four Bacillus strains with a range of concentration from 2.3 a 6.8 µg/ml, they achieved an increase in the germination and fresh mass of the tomato seedlings.
Bacillus subtilis GIBI 200 strain showed an auxin production and phosphate solubilization capacity although the strain did not show a significant effect (p<0.05) on the tomato seeds germination. The results obtained do no correspond to those reported by Lagunas et al. (2001); Izzeddin and Medina (2011); Luna-Martínez et al. (2013), who showed that the inoculation of tomato seeds with the Bacillus strains increase the germination percentages in 5 or 6 %.
The seed germination depends on the viability of the embryo and the breaking of dormancy generated by environmental conditions (Luna-Martínez et al., 2013). The PGPB can influence the latter case since the reduction in ethylene levels due to the ACC deaminase activity of bacteria in the seed increases germination, along with the production of IAA that stimulates cell division in order to promote the growth of the embryo (Glick et al., 2007; Jalili et al., 2009).
With regard to growth, it was found that the strain Bacillus subtilis GIBI 200 has plant growth promoting effect on 37-day-old tomato seedlings, with significant increases (p≤ 0.05) in length and fresh weight of stem and root. The results coincide with those reported by other authors who demonstrated the positive effect of inoculation of tomato plants with strains of Bacillus (Lagunas et al., 2001; Luna Martinez et al, 2013). And other bacterial genera such as Azospirillum (Terry-Alfonso et al., 2005), Pseudomonas (Gravel et al., 2007) and Rhizobium (Santillana et al., 2005). This behavior could be related to the production of metabolites of IAA type by the inoculated strain. The IAA induces plant growth by increasing cell division and differentiation of tissue, effects that are reflected in a higher content of biomass (Lagunas et al., 2001; Santillana et al., 2005). It has also been argued that the IAA absorbed by the seeds and roots of plants could stimulate the activity of the ACC synthase enzyme, which is involved in the synthesis of ethylene. Low ethylene concentrations promote the growth of root hairs of inoculated plants and the surface area of the root (Luna Martinez et al., 2013), which brings increase in water and nutrient intake by the plant, thereby increase in plant growth.
CONCLUSIONS
Bacillus subtilis GIBI 200 promotes the growth of tomato. The major effects of inoculation of the strain were observed in the increase of length and fresh weight of stem and root in young plants. This could be related to the production of indole compounds of IAA type and solubilization of phosphate by the strain; however, other mechanisms could be influencing the beneficial effects obtained in vivo, although other experiments should be developed to demonstrate this hypothesis. The results indicate the agro-biological capabilities of Bacillus subtilis GIBI 200 and its potential use as a microbial inoculant on tomato crop.
CONFLICT OF INTEREST
The authors declare that they have not conflict of interest.
Acknowledgments
The authors express their sincere gratitude to the Directorate of Research and Graduate Studies at the Catholic University of Manizales for the funding provided for the development of this research, according to Agreement No 9 January 27, 2011, issued by the Academic Council.
References
Acebo-Guerrero Y, Hernández-Rodríguez A, Vandeputte O, Miguélez-Sierra Y, Heydrich-Pérez M, Ye L, El Jaziri, M. Characterization of Pseudomonas chlororaphis from Theobroma cacao L. rhizosphere with antagonistic activity against Phytophthora palmivora (Butler). J Appl Microbiol. 2015;119(4):1112-1126. Doi: 10.1111/jam.12910.
Arie T, Takahashi H, Kodama M, Teraoka T. Tomato as a model plant for plant-pathogen interactions. Plant Biotechnol. 2007;24(1):135-147. Doi: 10.1007/978-3-642-60234-4_2
Bashan Y, Holguin G. Proposal for the division of Plant Growth- Promoting Rhizobacteria into two classification: biocontrol-PGPB (Plant Growth-Promoting Bacteria) and PGPB. Soil Biol Biochem. 1998;30(8-9):1225-1228.
Cabra-Cendales T, Meneses-Cabezas DC, Galeano-Vanegas NF. Identificación de microorganismos asociados a residuos de higuerilla (Ricinus communis). Rev Colomb Quim. 2015;44(2):10-15. Doi: 10.15446/rev.colomb.quim.
Camargo-Cepeda DF, Ávila ER. Efectos del Trichoderma sp. sobre el crecimiento y desarrollo de la arveja (Pisum sativum L.). Ciencia y Agricultura. 2014;11(1):91-100.
Camelo M, Vera SP, Bonilla RR. Mecanismos de acción de las rizobacterias promotoras del crecimiento vegetal. Corpoica cienc tecnol. Agropecu.2011. Available in: http://agris.fao.org/agris-search/search/display.do?f=2012/CO/CO1201.xml;CO2012003937 Accessed.
Ceballos-Aguirre N, Vallejo-Cabrera FA, Arango-Arango N. Evaluación del contenido de antioxidantes en introducciones de tomate tipo cereza (Solanum spp). Acta Agron. 2012;61(3):230-238.
Chandler S, Van Hese N, Coutte F, Jacques P, Höfte M, De Vleesschauwer D. Role of cyclic lipopeptides produced by Bacillus subtilis in mounting induced immunity in rice (Oryza sativa L.). Physiol Mol Plant P. 2015; 91:20-30. Doi: 10.1016/j.pmpp.2015.05.010.
Cubillos JR, Castellanos DE, Argüello H. Selección de Microorganismos promotores de crecimiento vegetal (ácido indol acético) a partir de muestras de suelo rizosferico, como primera etapa en el desarrollo de un biofertilizante. Rev Bras Agroecol. 2009;4(2):páginas.
Estrada GA, Divan Baldani VL, de Oliveira DM, Urquiaga S, Baldani JI. Selection of phosphate-solubilizing diazotrophic Herbaspirillum and Burkholderia strains and their effect on rice crop yield and nutrient uptake. Plant Soil. 2013;369:115-129. Doi: 10.1007/s11104-012-1550-7.
Felici C, Vettori L, Giraldi E, Forino LMC, Toffanin A, Tagliasacchi AM, Nuti M. Single and co-inoculation of Bacillus subtilis and Azospirillum brasilense on Lycopersicon esculentum: effects on plant growth and rhizosphere microbial community. Appl Soil Ecol. 2008;40(2):260-270. Doi: http://doi.org/10.1016/j.apsoil.2008.05.002.
Fernández LA, Zalba P, Gómez MA, Sagardoy MA. Bacterias solubilizadoras de fosfato inorgánico aisladas de suelos de la región sojera. Rev Cienc Suelo Nutr Veg. 2005;23(1):31-37.
Glick B R, Cheng Z, Czarny J, Duan J. Promotion of plant growth by ACC deaminase-producing soil bacteria. Eur J Plant Pathol. 2007;119(3):329-339.
Glickmann E, Dessaux Y. A critical examination of the specificity of the salkowski reagent for indolic compounds produced by phytopathogenic bacteria. Appl Environ Microbiol. 1995;61(2):793-796.
Gravel V, Antoun H, Tweddell RJ. Growth stimulation and fruit yield improvement of greenhouse tomato plants by inoculation with Pseudomonas putida or Trichoderma atroviride: possible role of indole acetic acid (IAA). Soil Biol Biochem. 2007;39(8):1968-1977.
Gül A, Kidoglu F, Tüzel Y. Effects of nutrition and Bacillus amyloliquefaciens on tomato (Solanum lycopersicum, L.) growing in perlite. Span J Agric Res. 2008;6(3):422-429.
Hernández-Rodríguez A, Ruíz-Beltrán Y, Acebo-Guerrero Y, Miguélez-Sierra Y, Heydrich-Pérez M. Microbial antagonists to manage black pod rot in Theobroma cacao L. Their present status and perspective use in Cuba. Rev Protección Veg. 2014;29(1):11-19. Doi: 101159/000207196. 11.
Izzeddin N, Medina L. Efecto del control biológico por antagonistas sobre fitopatógenos en vegetales de consumo humano. Salus. 2011;15(3):8-18.
Jalili F, Khavazi K, Pazira E, Nejati A, Rahmani H A, Sadaghiani H R, Miransari M. Isolation and characterization of ACC deaminase-producing fluorescent pseudomonads, to alleviate salinity stress on canola (Brassica napus L.) growth. J Plant Physiol. 2009;166(6):667-674. Doi: 10.1007/s11103-008-9435-0.
Kaur G, Reddy MS. Influence of P-solubilizing bacteria on crop yield and soil fertility at multilocational sites. Eur J Soil Biol. 2014;61:35-40. Doi: 10.1046/j.1351-0754.2003.0567.x.
Kennedy IR, Choudhury AT, Kecskes ML. Non-symbiotic bacterial diazotrophs in crop-farming systems: can their potential for plant growth promotion bebetter exploited?. Soil Biol Biochem. 2004;36(8):1229-1244.
Kloepper JW, Metting Jr FB. Plant growth-promoting rhizobacteria as biological control agents. Soil microbial ecology: applications in agricultural and environmental management.1992:255-274.
Lagunas-Lagunas J, Zavaleta-Mejía E, Osada-Kawasoe S, Aranda-Ocampo S, Luna-Romero I, Vaquera-Huerta H. Bacillus firmus como agente de control biológico de Phytophthora capsici Leo. en jitomate (Lycopersicon esculentum Mill.). Rev Mex Fitop. 2001;19(1):57-65.
Luna-Martínez L, Martínez-Peniche RA, Hernández-Iturriaga M, Arvizu-Medrano SM, Pacheco-Aguilar JR. Caracterización de rizobacterias aisladas de tomate y su efecto en el crecimiento de tomate y pimiento. Rev Fitotec Mex. 2013;36(1):63 - 69.
Mehta S, Nautiyal CS. An Efficient Method for Qualitative screening of Phosphate-Solubilizing Bacteria. Curr Microbiol. 2001;43:51-56.
Morales FJ, Tamayo PJ, Castaño M, Olaya C, Martínez AK, Velasco AC. Enfermedades virales del tomate (Solanum Lycopersicum L.) en Colombia. Fitopatología Colombiana. 2009;33(1):23-27.
Myresiotis CK, Vryzas Z, Papadopoulou-Mourkidou E. Enhanced root uptake of acibenzolar-S-methyl (ASM) by tomato plants inoculated with selected Bacillus plant growth-promoting rhizobacteria (PGPR). App Soil Ecol. 2014;77:26-33. Doi: http://doi.org/10.1016/j.apsoil.2014.01.005.
Reis VM, Baldani VLD, Baldani J I. Isolation, identification and biochemical characterization of Azospirillum spp. and other nitrogen-fixing bacteria. In Handbook for Azospirillum. Switzerland: Springer International Publishing. 2015. p. 3-26.
Reyes I, Alvarez L, El-Ayoubi H, Valery A. Selección y evaluación de rizobacterias promotoras del crecimiento en pimentón y maíz. Bioagro. 2008;20(1):37-48.
Rojas MM, Tejeda B, Larrea JA, Mahillon J, Heydrich M. Aislamiento y caracterización de cepas de Bacillus asociadas al cultivo del arroz (Oryza sativa L.). Rev Bras Agroecol. 2011;6(1):90-99.
Santillana N, Arellano C, Zúñiga D. Capacidad del Rhizobium de promover el crecimiento en plantas de tomate (Lycopersicon esculentum Miller). Ecol Appl. 2005;4(4):1-2. Doi: 10.1111/1365-2664.12845.
Terry-Alfonso E, Leyva-Galán A, Hernández-Rodríguez A. Microorganismos benéficos como biofertilizantes eficientes para el cultivo del tomate (Lycopersicon esculentum, Mill). Rev Colomb Biotecnol. 2005;7(2):47.
Tien TM, Gasking MH, Hubbell DH. Plant growth substance produced by Azospirillum brasilense and their effect on the growth of pearl millet (Pennistem americanun L.) Appl. Environ Microbiol. 1979;37(4):219-226.
Tsavkelova EA, Klimova SY, Cherdyntseva TA, Netrusov AI. Microbial producers of plant growth stimulators and their practical use: a review. Appl Biochem Microbiol. 2006;42(2): 117-126. Doi: 10.1134/S0003683806020013.
Whipps JM. Microbial interactions and biocontrol in the rhizosphere. J Exp Bot. 2001;52: 487-511.
Widnyana-Ketut I, Cokorda Javandira. Activities Pseudomonas spp. and Bacillus sp. to stimulate germination and seedling growth of tomato plants. Agric Agric Sci Procedia. 2016;9:419-423. Doi: 10.1016/j.aaspro.2016.02.158
Author notes
tcabra@ucm.edu.co